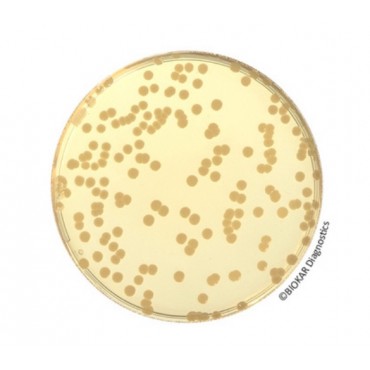
Gélose pour dénombrement...

Milieux de Culture - réactifs et trousses de performance
Milieux de Culture - réactifs et trousses de performance
FILTRE PAR
Catégories
Marque
Milieux de Culture - réactifs et trousses de performance
Innovation Diagnostics propose une large gamme de milieux de culture, de réactifs et de matériel de référence pour tous les laboratoires de microbiologie.
Notre gamme innovante de milieux de longue durée pour l'industrie pharmaceutique, le système InstantBag pour l'intégration de bouillon prêt à l'emploi avec notre solution de préparation d'échantillons et notre gamme complète de milieux de culture déshydratés ne sont que quelques exemples de l'étendue de notre portefeuille de produits.
Notre partenariat avec des fabricants renommés nous permet d'offrir un mélange unique de milieux conventionnels, chromogéniques et de longue durée pour une large gamme d'applications industrielles et cliniques.
Filtres actifs
- Catégories : Milieux prêts à l'emploi